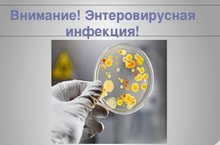

Муниципальное бюджетное общеобразовательное учреждение «Хозесановская средняя общеобразовательная школа Кайбицкого муниципального района РТ"/ "Татарстан Республикасы Кайбыч муниципаль районы Хуҗа Хәсән гомуми урта белем бирү мәктәбе" муниципаль бюджет белем бирү учреждениесе
Визитная карточка
| Адрес: | 422326, РТ, Кайбицкий район, с. Хозесаново, ул. Школьная, д.23 |
| Телефон: | +7(843)-703-52-12 |
| E-Mail: | Shoz.Kbc@tatar.ru, sch726@rambler.ru |
| Министерство: | Министерство образования и науки Республики Татарстан |
| Короткое название: | МБОУ "Хозесановская СОШ" |
| Руководитель: | Макарова Надежда Николаевна |
| Год основания учреждения: | 1926 |
| У нас учатся: | 64 обучающихся |
| У нас учат: | 14 учителей |
Муниципальное бюджетное общеобразовательное учреждение «Хозесановская средняя общеобразовательная школа Кайбицкого муниципального района РТ"/ "Татарстан Республикасы Кайбыч муниципаль районы Хуҗа Хәсән гомуми урта белем бирү мәктәбе" муниципаль бюджет белем бирү учреждениесе - новости
Страницы: << 41 42 43 44 45 46 ( 47 ) 48 49 50 >>
-
Осень - пора сбора урожая. 18.09.2021

Осень - время сбора урожая. На пришкольном участке выращены плоды. Без сочной, сладкой морковки не обходится ни одна кухня мира. Но мало вырастить богатый урожай, очень важно вовремя и правильно собрать его. Урожай у нас хорош!!!
-
Осенние работы. 17.09.2021

Осенние дни благоприятны для работы на пришкольном участке.. Сегодня в школе был проведен трудовой десант по сбору урожая свеклы. Свекла уродилась несмотря на засушливое лето.
-
Кросс нации 2021 17.09.2021

Ежегодно в сентябре проводится в нашей школе "Кросс нации ". Сегодня в рамках Всероссийского дня бега «Кросс нации 2021» учащиеся 1-11 классов соревновались за призовые места. В здоровом теле - здоровый дух.
-
Осторожно! Энтеровирусная инфекция 15.09.2021
Энтеровирусная инфекция — группа острых инфекционных заболеваний, вызываемых различными серотипами энтеровирусов. Характеризуется многообразием клинических проявлений с возможным поражением практически всех органов и систем. Профилактика:
- выявлять и изолировать больных на ранней стадии болезни;
- чаще мыть руки, обязательно после уборной и перед едой;
- употреблять для питья только кипячёную и проверенную воду;
- в пищу употреблять по возможности только качественную еду, прошедшую обработку;
- проводить влажную уборку и проветривание помещений, где мог быть больной;
- не использовать чужую посуду для еды и питья;
- стараться не глотать воду в бассейнах (концентрация хлора в ней не всегда соответствует норме, поэтому в воде могут сохраняться вирусы);
-
"Пушкинская карта" 14.09.2021

С 1 сентября в России начал действовать проект «Пушкинская карта». Благодаря ему молодые люди от 14 до 22 лет могут бесплатно посещать культурные мероприятия по всей стране.
Пушкинская карта — проект, направленный на то, что бы молодежь нашей страны могла за счет государства посещать различные культурные мероприятия. Те молодые люди, у которых будет Пушкинская карта, смогут оплачивать с нее посещение различных культурных мероприятий. Это могут быть походы на экскурсию, на концерт, в театр.
Чтобы оформить виртуальную карту и получать по ней билеты, нужно зарегистрироваться на «Госуслугах» и подтвердить учетную запись. Потом — установить мобильное приложение «Госуслуги.Культура» и получить «Пушкинскую карту».
-
Учебная эвакуация 13.09.2021

В рамках Месячника безопасности учитель ОБЖ Перепелкин А.А. провел с учащимися беседу по пропаганде мер противопожарной безопасности и учебную эвакуацию из здания школы. Классные руководители провели с обучающимися инструктажи.
-
Осенний субботник 11.09.2021

По всей стране с 4 по 25 сентября проходит Всероссийская экологическая акция «Зеленая Россия». Акция направлена на бережное отношение к природе, способ объединить общество, пробудить ответственность в каждом. Направлено на патриотическое воспитание подрастающего поколения.
Чтобы поддержать идеи не только сбережения природы, но и экологического и патриотического воспитания, не осталась в стороне и наша школа.
Субботник в очередной раз доказал, что вместе мы готовы сделать многое, чтобы наша планета была самой красивой и чистой !
-
"Татарча диктант" 2021 10.09.2021
Бүген Хуҗа Хәсән мәктәбе укытучылар коллективы, хезмәткәрләре, укучылары “татарча диктант” бөтендөнья белем бирү акциясендә катнаштылар.“Татарча диктант“ 2016 елдан бирле уздырылып килә. Быел диктантны алдан билгеләнгән пунктларга барып та, ТНВ, “ТНВ-Планета“ каналлары ярдәмендә язарга мөмкинлек булды. Диктант халык язучысы Гомәр Бәширов истәлекләре буенча иде. Ул анда композитор Сара Садыйкова белән “Җидегән чишмә“ җыры язылу тарихын бәян иткән. -
Башлангыч сыйныфларда ата-аналар җыелышы 10.09.2021

Хуҗа Хэсән гомуми белем бирү мәктәбенең башлангыч сыныфларында ата-аналар җыелышы булып узды. Җыелыш «Гаиләдәге мөнәсәбәтләр» дигән темага багышланган иде. Җыелышта тема белән бәйле ситуацияләрне (килеп чыккан хәлләрне) чишеп карадылар. Бу — үз чиратында гаиләдә бала тәрбияләгәндә еш очрый торган мәсьәләләрне хәл итәргә булышыр!
-
Татарча диктант Яз! 08.09.2021

С 10 по 12 сентября в России пройдет всемирная образовательная акция «Татарча диктант». Проверить знания по татарскому языку смогут все желающие, информирует пресс-служба мэрии Казани.
Основным днем проведения акции в Татарстане и Башкирии станет 10 сентября, в других регионах — 11-е число, а за рубежом — 12-е.






